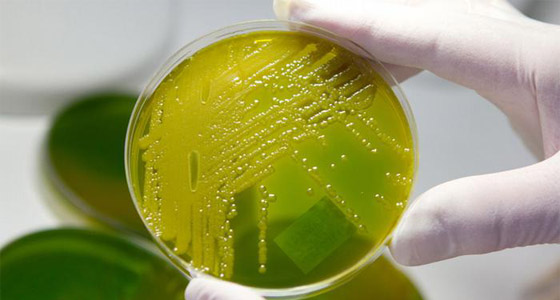

نعرف ان هناك أماكن تكثر فيها أنواع خطيرة من جراثيم و ميكروبات تسبب الامراض بل الوفاة أحيانا. المشكلة هي انه يمكن إيجاد الجراثيم الخطيرة في كل مكان تقريباً وحتى في أماكن لم تخطر ببالك ابدا.. فهل خطر ببالك ان بعض نوافذ البيت تحوي من ميكروبات وفطريات اكثر مما يحتويه مقعد المرحاض؟ وهل تعلم ان سنتمترا مربعا واحدا في طاولة المكتب يحوي 3000 جرثومة! وما رأيك بأن الأوراق المالية والعملات المعدنية هي أيضاً مرتع للجراثيم! وكذلك مقابض الأبواب والثلاجة.. اما لوحة مفاتيح الكمبيوتر فهي أكثر الأماكن تلوثاً. اليكم المزيد من التفاصيل في الصور التالية:
ليست كل الجراثيم مضرة بالصحة. ففي حالة بكتيريا السالمونيلا التي ينقلها البيض الفاسد، فإن الشخص السليم بحاجة
إلى تناول مائة بيضة فاسدة ليمرض. أما في حالة بكتيريا الليجيونيلا (الفيلقية) التي تتكاثر قرب المسطحات
المائية في المناخ الحار والرطب، فيكفي فقط استنشاق مائة من تلك البكتيريا ليصاب الإنسان بالمرض.

من الغريب أن السنتيمتر المربع الواحد من مقعد المرحاض يحتوي على أقل من عشرة ميكروبات، وبذلك يعتبر
هذا أحد "أنظف" الأماكن في البيت، إذ يمكن لبعض النوافذ مثلاً أن تؤوي عدداً أكبر بكثير من الميكروبات
والفطريات، ذلك أنها تنظف مرة كل ستة أشهر.

مكان العمل يعتبر مرتعاً للبكتيريا ونواقل الأمراض، إذ يصل معدل الميكروبات في السنتيمتر المربع الواحد من
طاولة المكتب إلى ثلاثة آلاف جرثومة، أي أكثر بأربعمائة مرة من مقعد المرحاض. وفي مكان العمل، تعتبر
لوحة مفاتيح الكمبيوتر أكثر الأماكن تلوثاً بالبكتيريا والجراثيم.

الأوراق المالية والعملات المعدنية تعتبر أيضاً مرتعاً للجراثيم، ذلك أنها تنتقل من يد إلى يد ومن شخص إلى آخر.
وتعرف باحثون من نيويورك على ثلاثة آلاف نوع من البكتيريا موجودة على الأوراق المالية. كما أمكن -
باستخدام طرق قياس دقيقة - التعرف على آثار للكوكايين على بعض الأوراق المالية!

الثلاجة أيضاً مخزن حقيقي للجراثيم، فدرجات الحرارة المتدنية والرطوبة داخلها تعتبر عوامل مثالية لنمو مسببات الأمراض،
ناهيك عن وجود الغذاء الكافي من دهون وسكريات، والتي تساعد أيضاً على نمو الفطريات، التي
يصعب التخلص منها حتى مع التنظيف المتكرر للثلاجة.

في المستشفيات، يجب الالتفات بشكل خاص إلى نظافة اليدين، ذلك أن تناقل أي مسببات للأمراض في المستشفيات
قد يعني خطر الموت. لذلك يحتوي الكثير من المستشفيات على موزعات لسوائل معقمة بجانب المغسلة،
والتي يُنصح باستخدامها بعد غسل اليدين بالماء والصابون.

هذه البكتيريا الخطيرة للغاية تعرف باسم (MRSA)، ولا تفيد ضدها أي مضادات حيوية. وحتى بدون غذاء يمكن
لهذه البكتيريا أن تصمد مدة تصل إلى سبعة شهور، سواء على أرض المنزل أو فوق الطاولة أو في السرير.

قامت عيادة في مدينة هامبورغ الألمانية بتنفيذ تجربة ناجحة تمكنت فيها من تقليل تواجد الجراثيم على مقابض
الأبواب من خلال استخدام مقابض نحاسية. وأظهرت التجربة انخفاض عدد الجراثيم على المقابض
المصنوعة من النحاس بنسبة النصف.

هل تعني هذه المعلومات التوقف عن مصافحة الناس؟ ربما يكون التخلي عن المصافحة في المستشفيات أمراً مستحباً، ولكن خارج المستشفيات يمكن الاستعاضة عن التخلي تماماً عن المصافحة بالانتباه أكثر إلى النظافة الشخصية، سواءً عن طريق غسل اليدين بانتظام أو تنظيف لوحة المفاتيح والفأرة في كمبيوتر العمل بشكل دوري، أو حتى عدم ملامسة المواد الغذائية بعد ملامسة الأوراق المالية والعملات المعدنية مباشرة.















